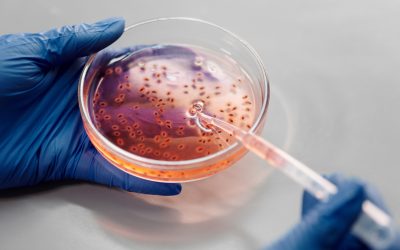

Aventures científiques

Expedicions
Expedicions a les illes Galápagos, a les muntanyes de Virunga, a una estació anàloga de Mart al desert de Utah i moltes més!
Segueix les expedicions de la mà dels científics i científiques que hi participen a través dels seus diaris de recerca!
Propera expedició… a l’Antàrtida! (novembre-desembre 2024).
Investiguem la neu i el gel al cor de l’Antàrtida!
jul. 11, 2024
VIU UNA EXPEDICIÓ A L'ANTÀRTIDA AMB LA TEVA CLASSE! L'Antàrtida és el continent més austral de la...
Explorem els coralls a les illes Galápagos!
juny 27, 2023
VIU UNA EXPEDICIÓ A LES ILLES GALÁPAGOS AMB LA TEVA CLASSE! Quines són les principals amenaces...
Viatgem al planeta Mart amb l'expedició LATAM-III
març 14, 2022
Voleu experimentar com seria viure al planeta Mart? Durant dues setmanes l'astrofísica Mariona...
Seguim la reproducció dels rapinyaires de la Serralada Litoral
abr. 3, 2018
Vols saber què passa a l’interior d’un niu d’àliga marcenca, d’astor o d’aligot vesper? ...
Aberigua: arqueologia colonial a l'illa de Guam
oct. 10, 2017
No! No hem fet cap falta d’ortografia! Així és com es diu “esbrina” en l’actual llengua chamorra....
Expedició a l'Antàrtida: natura i regulació del clima
gen. 18, 2017
Científics de 30 països de 6 continents, coordinats i patrocinats per l’Institut Polar Suís,...
Migradors de tardor
set. 20, 2016
Cada any milions d’ocells travessen Catalunya rumb al Sud, en un dels majors desplaçaments...
Investiga el planeta
abr. 21, 2016
Vivim al planeta Terra. A partir d’aquesta obvietat, podem observar i investigar nombrosos...
Madagascar, natura i biodiversitat al vuitè continent
gen. 12, 2016
Amb un territori que abraça menys del 2% de la superfície de tot l’Àfrica, l’illa de Madagascar...
Els petrells Gongon de l’illa de Fogo (Cap Verd)
febr. 19, 2015
El 18 de gener de 1832, 3 setmanes després de deixar Anglaterra, el Beagle s’aturava a Cap Verd,...
Hi ha Intel·ligència Artificial a la Terra?
gen. 20, 2015
Durant molts anys el programa SETI (Search for ExtraTerrestrial Intelligence) ha cercat vida...
Els goril·les de les muntanyes Virunga a Ruanda
ag. 25, 2014
Ja fa més d’un any que Jordi Galbany, antropòleg físic i primatòleg, va començar el projecte...
Investiguem la neu i el gel al cor de l’Antàrtida!
VIU UNA EXPEDICIÓ A L'ANTÀRTIDA AMB LA TEVA CLASSE! L'Antàrtida és el continent més austral de la...
Biologia Marina: Com afecta el canvi climàtic a la biodiversitat marina?
Pregunta formulada per l'Institut de Vilablareix. Resposta d’Ariadna Martínez del grup...
Explorem els coralls a les illes Galápagos!
VIU UNA EXPEDICIÓ A LES ILLES GALÁPAGOS AMB LA TEVA CLASSE! Quines són les principals amenaces...
Astrofísica: Si l’univers s’expandeix constantment i els estels i planetes s’allunyen cada vegada més entre ells, això no afecta l’hora de mesurar exactament el seu radi?
Pregunta formulada per l'Institut Puig Castellar (Santa Coloma de Gramenet). Resposta d'Ignasi...
Viatgem al planeta Mart amb l'expedició LATAM-III
Voleu experimentar com seria viure al planeta Mart? Durant dues setmanes l'astrofísica Mariona...
Epidemiologia: Hi ha cap altre cas de contagi de Coronavirus d’una altra espècie als humans que hagi produït pandèmies o epidèmies tan importants com l’actual?
Pregunta formulada per l'Institut Escola Mestre Andreu (Sant Joan de les Abadesses) Resposta de...
Epidemiologia: Com afecta la globalització al Coronavirus?
Pregunta formulada per l'Institut Deltebre (Deltebre) Resposta de Natàlia Rodríguez, investigadora...
Genètica: S’estan modificant gens defectuosos amb enginyeria genètica?
Pregunta formulada per l'Institut Manolo Hugué (Caldes de Montbui) Resposta de Gemma Marfany,...
Genètica: Podem heretar el càncer?
Pregunta formulada per l'Institut Mediterrània (El Vendrell) Resposta de Gemma Marfany,...
Robòtica: Què és el més difícil d’ensenyar a un robot?
Pregunta formulada per l'Institut Terres de Ponent (Mollerussa) Resposta de l'Anaís Garrell,...
Robòtica: Quines feines podrien fer els robots?
Pregunta formulada per l'Institut Torre Vicens (Lleida) Resposta de l'Anaís Garrell, investigadora...
Sostenibilitat: Com es pot descontaminar l’organisme?
Pregunta formulada per l'Institut de Montmeló (Montmeló) Resposta de Sílvia Lacorte, investigadora...